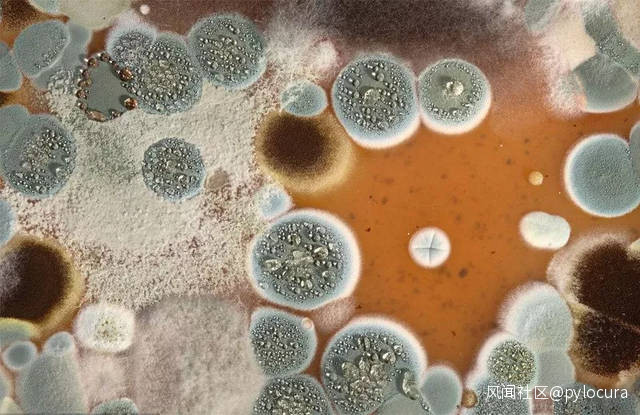

淨化室內空氣有8絕招 健康生活伴隨你_風聞
pylocura-2021-07-31 23:08
工業發展太快,嚴重破壞了環境,我們逐漸遠離了小時候親近的大自然。而日日夜夜都要呼吸的空氣,卻危害着我們的健康。受污染的大氣中含有多種污染物,當濃度達到一定程度時,就會造成急性污染中毒,或使病狀惡化,甚至在幾天內奪去幾千人的生命。
工業生產中排放的大量煙塵及汽車尾氣中含有致癌物二硝苯芘,煤炭、草木、油類、瀝青等在不完全燃燒的條件下可產生苯並芘等多種致癌物,它們會引起多種癌症,尤其是肺癌。大氣污染對呼吸道疾病、心血管疾病都有顯著影響。不想讓日益惡化的空氣奪去健康,就要時刻淨化身邊的空氣。
淨化室內空氣有8招
1、過濾空氣
空氣過濾能有效減少微粒對肺部的影響。利用具有過濾網的循環裝置過濾空氣,可以儘量多的過濾掉微粒。對人體總會有益處。經常更換濾芯也有助於空氣清潔。在如今空氣質量不斷下降的情況下,選擇一台空氣淨化器也是一個方法,帶有過濾器的空調效果更好。
2、關閉窗户

臭氧及其他類型的空氣污染,以及户外的致敏物及灰塵,會給肺部帶來影響。尤其在容易過敏的季節情況更甚。如果狂風呼嘯或生活在一個灰塵容易積聚的地方,就更要小心。在空氣高度污染的日子要緊閉窗子。你也可以通過上網查看監控數據來了解空氣質量。要記住的是,你在清掃時,可能需要打開窗子去清除空氣中的化學清潔劑。
3、控制寵物皮屑
寵物皮屑對哮喘的危險很大。因為皮屑微粒通常較大,不會進入呼吸道。但是容易誘發過敏症,也會加劇呼吸困難問題。狗、貓、鳥類均能構成威脅(而魚不會)。如果你正飼養着寵物,或者你覺得某種動物對你保持心理健康很有必要,至少要做到侍弄寵物後洗手,且不要把寵物帶進卧室。
4、切斷化學物質

這似乎是個難題:你既要清除灰塵和寵物皮屑,但味道過重的清潔劑或許會成為新的過敏源。邁入剛清潔過的房間也或會造成問題,即便佩戴口罩也未必管用。這就要求選用食醋或老式肥皂及清水,基本原則是選用沒有芳香氣味的東西。還要避免使用髮膠、香水、膠水、油漆和空氣清新劑。若是要清新的空氣,就要去對它進行清潔,而非是用另一種味道去覆蓋。
5、遠離塵蟎
與人一樣,塵蟎喜歡藏身於牀墊和寢具裏。塵蟎能誘發哮喘,加劇肺部疾病。推薦使用防蟲牀墊和枕套,這些牀墊和枕套通常也具有防蟎功能。選用泡沫乳膠枕芯,而不是鵝絨或羽毛枕芯。用熱水(54℃以上)清洗亞麻製品,至少每週一次,也能抑制塵蟎。
6、防止黴變和黴菌
卧室和浴室良好的通風系統能減少黴變,黴變也是造成肺部疾病的誘因。因為塵蟎也喜歡潮濕。你要把房間濕度保持在一個相對較小的範圍,大約40%。為減少濕度,可以考慮採用抽濕器且避免使用加濕器或蒸餾器。
7、遠離吸煙者
多數肺病的原因都是吸煙所致。不論你確診前是否抽煙,你都要遠離二手煙(或一手煙)。吸煙和被動吸煙都要絕對加以避免。戒掉煙癮非常不易,這已不是一個秘密。但如果你患有肺部疾病卻仍在吸煙,風險就增大許多。只有戒煙才能避免造成更大損傷,否則,疾病發展更快。
8、鍛鍊但莫過量

鍛鍊是件好事情。但是,如果你所處的環境惡劣,過量運動會引發呼吸困難。你需要鍛鍊,但你也不必跨着一個裝滿髒衣服的重籃子直上直下的爬樓梯。如果你真的這樣做了,可能會引起麻煩。